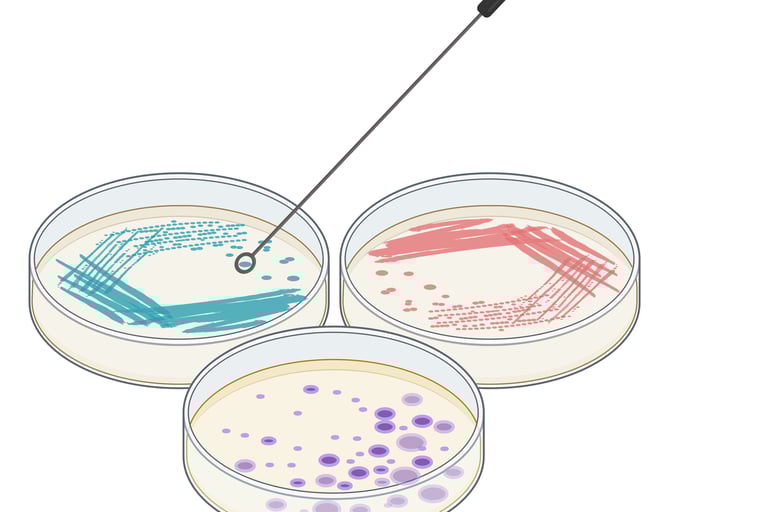
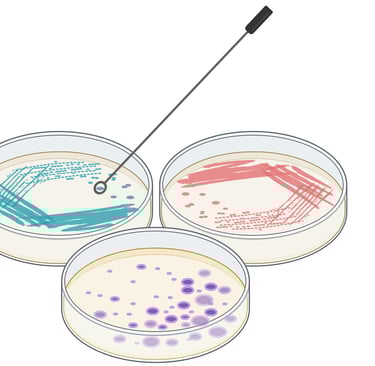

Our Services
AegisGreen provides integrated environmental, analytical, and compliance focused services designed to support organizations across the full project lifecycle from initial assessment and testing to implementation, verification, and long-term regulatory alignment.
Our multidisciplinary approach allows us to address complex challenges holistically, ensuring solutions are scientifically sound, regulator-ready, and practical to implement.
How Our Services Work Together
At AegisGreen, our services are designed to function as an integrated system, not as isolated offerings. Clients may engage us for a single, targeted service or partner with us across multiple stages of a project lifecycle ensuring continuity, technical clarity, and regulatory confidence from start to finish.
Assess & Test: We begin with analytical, microbial, and environmental evaluations, including sampling, monitoring, and testing of water, soil, materials, and emerging contaminants such as PFAS, to establish a defensible technical baseline.
Plan & Validate: Using research-driven strategies, risk assessments, and pilot or feasibility
studies, we design practical solutions that align scientific findings with regulatory requirements and site-specific conditions.
Implement & Verify: We support implementation through compliance-aligned execution, including SPCC, SWPPP, RCRA, and Clean Water Act programs, remediation support, and documentation that stands up to regulatory and audit scrutiny.
Support & Train: We provide ongoing technical support, training, audits, and knowledge transfer to equip client teams for sustained performance, continuous improvement, and long-term regulatory readiness.

This integrated approach ensures defensible outcomes, reduced risk, and seamless transitions between assessment, planning, implementation, and compliance delivering solutions that work in the real world.
Who We Support
AegisGreen partners with organizations across the public and private sectors that require scientifically sound, regulator ready environmental solutions. Our services support a broad range of clients, including:
Water and wastewater utilities, supporting monitoring, treatment evaluation, compliance, and emerging contaminant management
Manufacturing and chemical industries, providing environmental compliance, PFAS management, EHS systems, and risk mitigation
Environmental and remediation firms, delivering analytical support, sampling, validation, and technical collaboration
Research institutions and laboratories, supporting applied research, microbial and environmental testing, and material development
Public-sector and regulatory-facing organizations, assisting with monitoring programs, documentation, audits, and compliance readiness
This diverse engagement enables AegisGreen to bridge science, regulation, and practical implementation across complex environmental projects.
